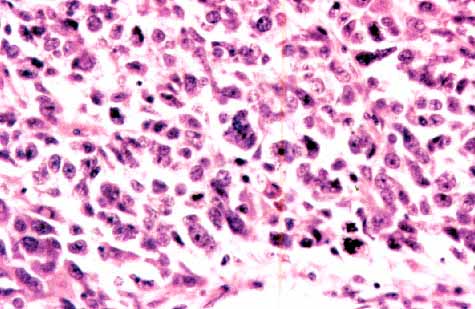
foto 3

Póster
Nş 073
Póster |
Miguel Angel Limeres González, Pilar de la Rosa del Rey, Ana Alonso Fernández-Aceytuno
 |
| Foto nş 1: Pieza de antrectomía. Obsérvese en el extremo de la superficie de corte la continuidad del tumor con la pared gástrica y como en el lado opuesto constituye una masa heterogénea. |
 |
| Foto nş 2: Carcinoma pobremente diferenciado en relación con la mucosa gástrica antral. |
|
| Foto nş 3: Detalle de las áreas menos diferenciadas del tumor. Destaca la anaplasia, el índice mitósico y la prominencia del nucléolo. |
 |
| Foto nş 4: Área de patrón hepatoide. Se puede apreciar una tendencia a la disposición trabecular. |